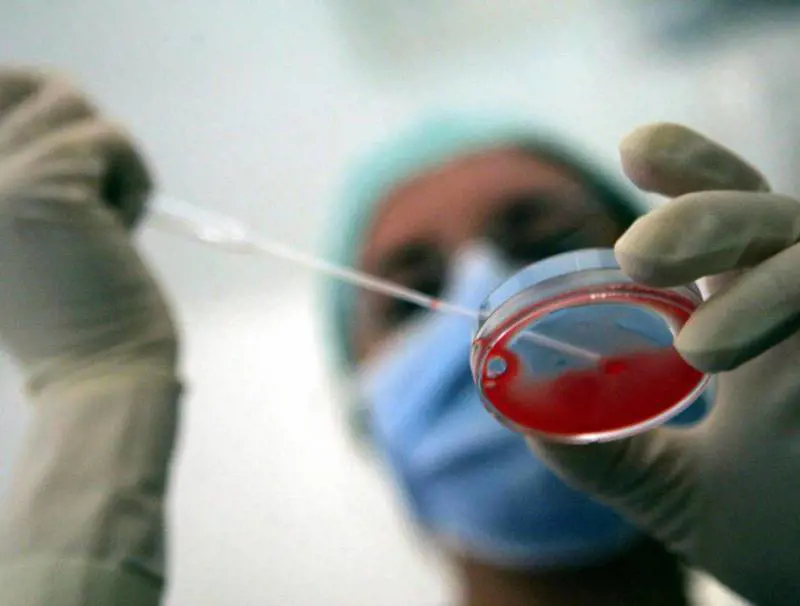

Londra - «Se sei una ragazza compassionevole, gentile, in salute, di età tra i diciotto e i trentacinque anni, ci aiuteresti a metter su famiglia?. Noi, per i tuoi ovuli, ti offriamo 750 sterline», che in euro fanno novecento e rotti.
Ha questi toni il volantino che nei giorni scorsi migliaia di studentesse dell’ateneo inglese di Cambridge si sono ritrovate nella posta e consegnate da una società chiamata «Altrui» specializzata nell’ovodonazione con base ad Hawes, nel North Yorkshire. Sembrava essere una lacrimosa richiesta d’aiuto da parte di una famiglia che non poteva avere figli a causa di un raro disturbo genetico e che quindi cercava «un angelo in grado di donarle degli ovuli». Peccato che il volantino fosse distribuito e prodotto da una coppia, moglie e marito, ufficialmente titolari di una associazione profit di intermediazione che si occupa di trovare dei donatori per coppie sterili e che si pagare lautamente.
A queste coppie disperate l’organizzazione chiede ben 1.300 sterline alle quali si aggiungono altre 750 che gli aspiranti genitori devono consegnare al donatore come «risarcimento», unica via legalmente consentita per ottenere del denaro in cambio di ovuli, dato che in Gran Bretagna la donazione a pagamento è ancora severamente vietata mentre la pratica della «compensazione» è stata recentemente autorizzata dalla Human Fertilisation and Embryology Authority.
Le 750 sterline che le donatrici dovrebbero ricevere non sono per l’ovulo, ma per tutti i problemi che una donazione comporta in termini di impegno, impegno, coinvolgimento fisico e morale. Il dettaglio finanziario però è alla base dell’inquietante diffusione di questo affare fondato sullo scambio di vite umane. Un business reso ancor più appetibile anche dalla possibilità di selezionare le donatrici per ottenere dei «superbambini». Chi desidera un figlio e non è in grado di averlo ora può anche decidere di volerlo particolarmente bello o intelligente.
Come una studentessa dei migliori college di Londra che ha l’unico difetto di essere a corto di soldi e quindi meglio disposta di altre a donare qualche ovulo.
L’iniziativa ha scatenato non poche polemiche all’interno della società britannica. Molti esperti hanno definito inaccettabile il volantino di «Altrui» spiegando che molto spesso le donatrici non sono consapevoli dei rischi di una simile donazione, né del fatto che per stimolare la produzione saranno costrette a trattamenti che possono rivelarsi anche dannosi per la loro salute.
Senza contare poi, il lato etico della questione. «Alla fine qui non si tratta di donazione, ma di un vero mercato di ovuli umani»- ha dichiarato al Daily Mail Josephine Quintavalle, del gruppo “Comment on Reproductive Ethics” - bisogna tener conto delle implicazioni eugenetiche di una simile procedura. Vengono scelti gli ovuli delle studentesse migliori perché i loro figli avranno una carriera scolastica brillante e quindi varranno di più nel mondo del lavoro». Ma queste sono regole imposte dal mercato che mal si conciliano con l’intento di trovare un angelo disposto a regalare un figlio ad una coppia sfortunata.
«Le donatrici dovrebbero farsi avanti volontariamente» suggerisce il dottor Adam Balen della British Fertility Society, ma certo in cambio di 750 sterline le altruiste si moltiplicano.
«Le coppie che non possono avere figli sono moltissime e noi non possiamo fare questo lavoro gratis - si difende la fondatrice di “Altrui”, Alison Bagshawe, che ha perso il suo unico figlio di otto mesi a causa del cancro - abbiamo un mutuo da pagare e dobbiamo mangiare». Quanto alle studentesse, molte sarebbero rimaste tentate dall’offerta, ma al momento soltanto due si sarebbero effettivamente offerte.